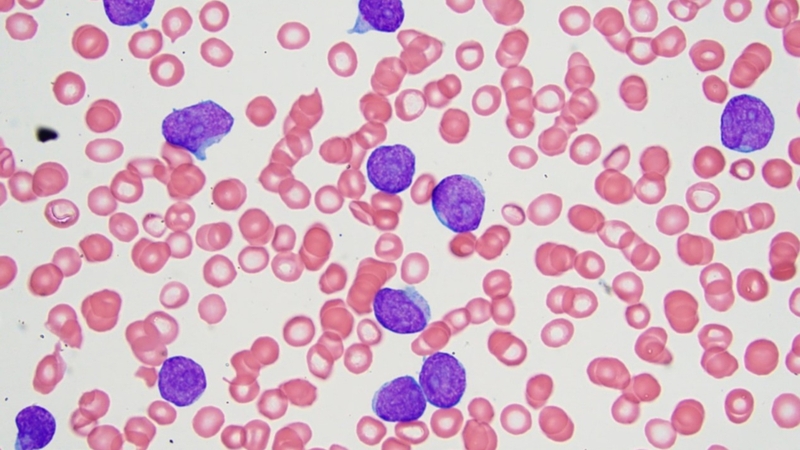
Bệnh bạch cầu lymphoblastic cấp tính và những điều bạn cần biết 2

Dược sĩ chuyên khoa Dược lý - Dược lâm sàng. Tốt nghiệp 2 trường đại học Mở và Y Dược TP. Hồ Chí Minh. Có kinh nghiệm nghiên cứu về lĩnh vực sức khỏe, đạt được nhiều giải thưởng khoa học. Hiện là Dược sĩ chuyên môn phụ trách xây dựng nội dung và triển khai dự án đào tạo - Hội đồng chuyên môn tại Nhà thuốc Long Châu.
Bệnh bạch cầu lymphoblastic cấp tính và những điều bạn cần biết
Bảo Yến
03/06/2025
Mặc định
Lớn hơn
Bệnh bạch cầu lymphoblastic cấp tính (ALL) là một dạng ung thư máu tiến triển nhanh, ảnh hưởng chủ yếu đến trẻ em nhưng cũng có thể xảy ra ở người lớn. Việc hiểu rõ về bệnh bạch cầu lymphoblastic cấp tính là điều cần thiết để phát hiện sớm và điều trị hiệu quả, giúp cải thiện tiên lượng và chất lượng cuộc sống cho bệnh nhân.
Bệnh bạch cầu lymphoblastic cấp tính (ALL) là loại ung thư máu phổ biến nhất ở trẻ em, chiếm khoảng 75 - 80% các trường hợp bạch cầu cấp tính ở nhóm tuổi này. Tại Việt Nam, mỗi năm có hàng trăm ca mắc mới ở trẻ em, với tỷ lệ mắc ước tính khoảng 1/100.000 người. Mặc dù đã có nhiều tiến bộ trong điều trị, tỷ lệ sống sót ở Việt Nam vẫn thấp hơn so với các nước phát triển, chủ yếu do hạn chế về kinh tế xã hội và khả năng tiếp cận dịch vụ y tế. Bài viết này sẽ cung cấp cái nhìn toàn diện về dịch tễ, triệu chứng, và các phương pháp điều trị hiện đại cho bệnh bạch cầu lymphoblastic cấp tính, nhằm nâng cao nhận thức và hỗ trợ bệnh nhân.
Định nghĩa và phân loại bệnh bạch cầu lymphoblastic cấp tính
Bệnh bạch cầu lymphoblastic cấp tính là một loại ung thư máu đặc trưng bởi sự tăng sinh không kiểm soát của các tế bào lymphoblast chưa trưởng thành trong tủy xương, dẫn đến việc thay thế các tế bào máu khỏe mạnh. Bệnh này thường ảnh hưởng đến trẻ em từ 2 - 5 tuổi nhưng cũng có thể xảy ra ở người lớn.

ALL được chia thành hai phân nhóm chính dựa trên loại tế bào lymphoblast bị ảnh hưởng:
ALL dòng B
Bạch cầu cấp dòng lympho (Acute Lymphoblastic Leukemia - ALL) dòng B là thể bệnh thường gặp nhất trong các loại ALL, chiếm khoảng 85% tổng số ca, đặc biệt ở trẻ em trong độ tuổi từ 2 đến 5 tuổi. ALL dòng B thường liên quan đến các bất thường di truyền, nổi bật là nhiễm sắc thể Philadelphia (t(9;22)), yếu tố có thể ảnh hưởng đến tiên lượng bệnh và quyết định phác đồ điều trị.
Đặc điểm lâm sàng và sinh học chính:
- Tỷ lệ mắc cao ở trẻ em, đặc biệt trong giai đoạn mẫu giáo.
- Có thể liên quan đến bất thường nhiễm sắc thể, như t(9;22) - đột biến này tạo ra gen BCR-ABL1, đóng vai trò trong bệnh sinh và kháng điều trị.
- Đáp ứng tốt với hóa trị, đặc biệt ở các trường hợp không mang đột biến nguy cơ cao, và có tỷ lệ sống cao hơn so với ALL dòng T.
ALL dòng T
Bạch cầu cấp dòng lympho (ALL) dòng T chiếm khoảng 15% tổng số ca ALL, và thường phổ biến hơn ở thanh thiếu niên và người lớn. So với dòng B, ALL dòng T có tiên lượng kém hơn, do đáp ứng điều trị chậm hơn, nguy cơ tái phát cao, và diễn tiến lâm sàng xâm lấn hơn.
Đặc điểm chính:
- Thường gặp ở nhóm tuổi lớn hơn, bao gồm thanh thiếu niên và người trưởng thành.
- Có thể liên quan đến bất thường nhiễm sắc thể như t(4;11) hoặc các bất thường phức tạp khác, ảnh hưởng đến sự biệt hóa tế bào T.
- Cần phác đồ hóa trị chuyên sâu và kéo dài hơn, đôi khi kết hợp ghép tế bào gốc tạo máu trong các trường hợp nguy cơ cao hoặc tái phát.
Phân loại FAB
Hệ thống phân loại FAB chia bạch cầu cấp dòng lympho (ALL) thành ba nhóm chính dựa trên hình thái học tế bào (kích thước, hình dạng nhân và bào tương):
- L1: Tế bào lympho nhỏ, đồng nhất, nhân tròn đều, bào tương ít. Đây là dạng phổ biến nhất ở trẻ em, đặc biệt tại các quốc gia phát triển.
- L2: Tế bào lớn hơn, không đồng nhất, nhân không đều, có thể có hạch nhân rõ, bào tương nhiều hơn. Dạng này thường gặp ở người lớn, tuy nhiên, tại Việt Nam, tỷ lệ trẻ em mắc ALL L2 cao hơn đáng kể (81,3%) so với trẻ em ở các nước phát triển như Bỉ (44,9%), cho thấy sự khác biệt về dịch tễ học giữa các khu vực.
- L3: Tế bào rất lớn, bào tương nhiều và có không bào rõ, nhân tròn và đều, điển hình của ALL dòng Burkitt (Burkitt-type). Đây là dạng hiếm gặp, liên quan đến ALL dòng B trưởng thành và thường có đặc điểm sinh học đặc thù.
Các yếu tố nguy cơ mắc bệnh bạch cầu lymphoblastic cấp tính
Một số yếu tố nguy cơ làm tăng khả năng mắc bạch cầu cấp dòng lympho (ALL) đã được xác định trong các nghiên cứu quốc tế. Về mặt di truyền, những trẻ mắc các hội chứng bẩm sinh như hội chứng Down, Fanconi anemia, ataxia telangiectasia, hoặc các rối loạn sửa chữa DNA khác có nguy cơ mắc ALL cao hơn do sự suy giảm cơ chế bảo vệ di truyền và miễn dịch.
Ngoài ra, yếu tố môi trường cũng đóng vai trò quan trọng, đặc biệt là phơi nhiễm với bức xạ ion hóa (từ điều trị ung thư trước đó hoặc tai nạn hạt nhân), và tiếp xúc với hóa chất độc hại như benzen, một chất có khả năng gây đột biến DNA và ảnh hưởng đến tế bào gốc tủy xương.
Bên cạnh đó, mặc dù hiếm gặp, tiền sử gia đình có người mắc bệnh bạch cầu cũng được ghi nhận là một yếu tố nguy cơ, đặc biệt trong các trường hợp có yếu tố di truyền trội trong gia đình. Việc nhận biết sớm các yếu tố nguy cơ có ý nghĩa quan trọng trong định hướng tầm soát và can thiệp sớm bệnh lý này.

Triệu chứng và phương pháp chẩn đoán
Nhận biết sớm các triệu chứng và áp dụng phương pháp chẩn đoán chính xác là yếu tố then chốt trong điều trị bệnh bạch cầu lymphoblastic cấp tính.
Triệu chứng thường gặp
Người mắc bạch cầu cấp dòng lympho (ALL) thường biểu hiện các triệu chứng toàn thân do sự thay thế và ức chế hoạt động bình thường của tủy xương, nơi sản xuất các tế bào máu khỏe mạnh. Khi tế bào lymphoblast bất thường gia tăng, tủy xương không còn đủ khả năng tạo ra hồng cầu, bạch cầu và tiểu cầu, từ đó dẫn đến thiếu máu, suy giảm miễn dịch và rối loạn đông máu.
Các triệu chứng thường gặp bao gồm:
- Mệt mỏi, da xanh xao hoặc nhợt nhạt, do thiếu hồng cầu.
- Sốt và nhiễm trùng tái phát, xuất phát từ tình trạng giảm bạch cầu và suy yếu miễn dịch.
- Chảy máu cam, chảy máu chân răng hoặc xuất huyết dưới da (bầm tím), do giảm tiểu cầu.
- Đau xương hoặc khớp, thường gặp ở trẻ nhỏ, do sự tích tụ tế bào bạch cầu trong tủy xương.
- Sưng hạch bạch huyết, gan hoặc lách to, do thâm nhiễm tế bào lymphoblast ngoài tủy xương.
Phương pháp chẩn đoán
Việc chẩn đoán bạch cầu cấp dòng lympho (ALL) đòi hỏi các xét nghiệm chuyên sâu nhằm xác định sự hiện diện và đặc điểm của tế bào lymphoblast - tế bào ác tính đặc trưng của bệnh. Chẩn đoán không chỉ giúp xác định loại bạch cầu cấp mà còn đóng vai trò quan trọng trong đánh giá tiên lượng và lựa chọn phác đồ điều trị phù hợp.
Các phương pháp chẩn đoán chính bao gồm:
- Xét nghiệm máu ngoại vi: Là bước đầu tiên giúp phát hiện các dấu hiệu gợi ý như giảm hồng cầu (thiếu máu), giảm tiểu cầu, hoặc thay đổi số lượng bạch cầu. Trong một số trường hợp, tế bào lymphoblast có thể được phát hiện trực tiếp trên lam máu.
- Chọc hút và sinh thiết tủy xương: Là tiêu chuẩn vàng để chẩn đoán xác định. ALL được chẩn đoán khi tỷ lệ tế bào lymphoblast chiếm >20% tổng số tế bào trong tủy xương, kèm theo đặc điểm hình thái và miễn dịch học đặc trưng.
- Xét nghiệm di truyền và sinh học phân tử: Bao gồm karyotype, FISH và PCR, giúp phát hiện các bất thường nhiễm sắc thể như nhiễm sắc thể Philadelphia (t(9;22)) hoặc t(4;11). Những thông tin này có giá trị tiên lượng và định hướng điều trị, đặc biệt trong việc sử dụng thuốc nhắm trúng đích.

Phác đồ điều trị và tiến bộ mới
Điều trị bệnh bạch cầu lymphoblastic cấp tính đòi hỏi phác đồ chuyên sâu và đa phương pháp.
Phác đồ điều trị chuẩn
Hóa trị là nền tảng chính trong điều trị bạch cầu cấp dòng lympho (ALL), với mục tiêu tiêu diệt tế bào ác tính và đạt được trạng thái lui bệnh hoàn toàn. Phác đồ điều trị thường được chia thành ba giai đoạn chính, được thiết kế để xử lý triệt để các tế bào leukemic qua từng giai đoạn bệnh.
Các giai đoạn điều trị bao gồm:
- Hóa trị cảm ứng: Là giai đoạn đầu tiên, kéo dài khoảng 4 - 6 tuần, nhằm tiêu diệt phần lớn tế bào leukemic và đưa bệnh về trạng thái lui bệnh về mặt huyết học.
- Hóa trị củng cố (consolidation): Được thực hiện sau giai đoạn cảm ứng, giúp tiêu diệt các tế bào còn sót lại trong tủy xương hoặc các cơ quan khác, giảm nguy cơ tái phát.
- Hóa trị duy trì: Là giai đoạn điều trị kéo dài từ 2 đến 3 năm, với liều thấp hơn, nhằm duy trì trạng thái lui bệnh và ngăn ngừa tái phát lâu dài.
Các liệu pháp bổ trợ quan trọng bao gồm:
- Liệu pháp nhắm trúng đích: Áp dụng cho các trường hợp ALL có nhiễm sắc thể Philadelphia (Ph+), với thuốc như imatinib, giúp cải thiện đáng kể tiên lượng và tăng tỷ lệ sống sót.
- Xạ trị: Thường được chỉ định khi có thâm nhiễm hệ thần kinh trung ương (CNS), và thường kết hợp với hóa trị tủy sống (intrathecal chemotherapy) để đạt hiệu quả tối ưu.
- Cấy ghép tế bào gốc tạo máu (HSCT): Được cân nhắc cho các trường hợp tái phát, không đáp ứng hoặc có nguy cơ rất cao, nhằm thay thế tủy xương bệnh lý bằng nguồn tế bào khỏe mạnh.

Tiến bộ mới
Những năm gần đây, sự phát triển vượt bậc trong lĩnh vực miễn dịch học và sinh học phân tử đã mở ra những lựa chọn điều trị tiên tiến cho bệnh nhân mắc bạch cầu cấp dòng lympho (ALL), đặc biệt là các trường hợp tái phát hoặc không đáp ứng với điều trị chuẩn.
Tiến bộ nổi bật bao gồm:
- Liệu pháp miễn dịch CAR-T (Chimeric Antigen Receptor T-cell): Đây là một bước đột phá trong điều trị ALL. Tế bào T của chính bệnh nhân được thu nhận và chỉnh sửa gen để biểu hiện thụ thể nhận diện kháng nguyên trên bề mặt tế bào leukemic (như CD19 ở ALL dòng B), sau đó được truyền trở lại cơ thể để tiêu diệt tế bào ác tính. Nhiều nghiên cứu cho thấy tỷ lệ lui bệnh cao, kể cả ở trẻ em và người lớn đã thất bại với các phác đồ điều trị trước đó.
- Thuốc nhắm trúng đích: Các tác nhân mới như blinatumomab (kháng thể hai đầu) và inotuzumab ozogamicin (kháng thể kết hợp thuốc) đã được chứng minh là cải thiện đáng kể tỷ lệ sống sót và kiểm soát bệnh, đặc biệt ở ALL dòng B có biểu hiện kháng nguyên CD19 hoặc CD22.
- Xu hướng giảm sử dụng xạ trị: Các nghiên cứu gần đây cho thấy rằng hóa trị tiêm vào tủy sống (intrathecal chemotherapy) có thể thay thế xạ trị toàn não trong phòng ngừa thâm nhiễm hệ thần kinh trung ương ở trẻ em, từ đó giúp giảm tác dụng phụ lâu dài như rối loạn phát triển và suy giảm nhận thức.
Bệnh bạch cầu lymphoblastic cấp tính là một thách thức lớn đối với hệ thống y tế, đặc biệt ở các nước đang phát triển như Việt Nam, nơi tỷ lệ sống sót vẫn thấp hơn so với các nước phát triển. Việc nâng cao nhận thức về triệu chứng, cải thiện chẩn đoán sớm, và áp dụng các tiến bộ y học như liệu pháp CAR-T và thuốc nhắm trúng đích là chìa khóa để cải thiện tiên lượng. Nếu bạn hoặc người thân có các triệu chứng như mệt mỏi, sốt, hoặc bầm tím bất thường, hãy đến cơ sở y tế để được kiểm tra kịp thời.
Có thể bạn quan tâm
Các bài viết liên quan
Bác sĩ cảnh báo 6 thói quen tiết kiệm có thể "rước" ung thư
Các loại virus gây ung thư thường gặp và cách phòng ngừa hiệu quả
Long Châu đồng hành cùng Tập đoàn IHH Singapore với buổi gặp gỡ chuyên gia từ Singapore với thông điệp "Phòng bệnh, chăm sóc và điều trị ung thư"
Tế bào ung thư là gì? Cơ chế hình thành và phát triển tế bào ung thư
Chụp CT có phát hiện ung thư dạ dày không? Các xét nghiệm khác để chẩn đoán ung thư dạ dày
Vi khuẩn ăn khối u ung thư đã ra đời, mở ra hướng điều trị mới
Ung thư nào chết nhanh nhất và vì sao diễn tiến lại nguy hiểm?
Ung thư di căn có chữa được không? Phương pháp điều trị ung thư di căn
Khám tầm soát ung thư là gì? Ai nên thực hiện?
Đề xuất bổ sung nhiều thuốc vào danh mục chi trả bảo hiểm y tế, trong đó có 30 thuốc điều trị ung thư
:format(webp)/Option_1_2_2d9677e5fd.png)
:format(webp)/Option_1_1_2a84e0cd00.png)
:format(webp)/tran_huynh_minh_nhat_905ca436dd.png)